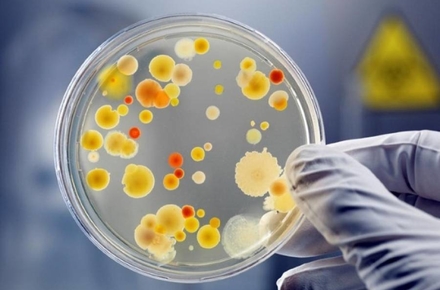

Майже у 5% протестованих працівників харчоблоків у закладах освіти Житомирської області виявили стафілокок.
Про це 21 жовтня повідомила пресслужба Міністерства охорони здоров’я.
«11 жовтня регіональні Центри контролю та профілактики хвороб МОЗ України розпочали раптові перевірки працівників харчоблоків у закладах освіти на носійство золотистого стафілокока. За 8 днів перевірок (станом на 19 жовтня) загалом обстежено 9117 осіб. Раптові перевірки відбулися в 3002 закладах. За результатами обстежень 940 осіб (10%) мають позитивний результат тесту на носійство стафілококу. Що стосується Житомирщини, то на 19 жовтня було обстежено 206 осіб. За результатами обстежень 10 осіб мають позитивний результат тесту на носійство стафілококу. Виявлені носії інфекцій будуть відсторонені від роботи на час лікування й до повного одужання. Ще 71 результат дослідження очікується. Раптові перевірки відбулися у 65 закладах», - йдеться у повідомленні.
Як зазначили в МОЗ, перевірки здійснюють державні установи — центри контролю та профілактики хвороб МОЗ України та ДУ «Житомирський обласний лабораторний центр МОЗ України». Перевірки здійснюються на виконання постанови головного державного санітарного лікаря України від 07.10.2021 № 15 «Щодо організації проведення позачергових обстежень працівників харчоблоків закладів освіти, дитячих закладах оздоровлення та відпочинку, дитячих будинках-інтернатах у зв’язку погіршення епідемічної ситуації».
Як повідомляв Житомир.info, 2 березня 2021 року в житомирській школі № 20 зареєстрували гостру кишкову інфекцію. За попередніми даними було відомо, що захворіло 9 учнів. Навчання у школі призупинили з третього березня. Спеціалісти Держпродспоживслужби та лабораторного центру проводили комплекс протиепідемічних заходів у вогнищі. Для лабораторних досліджень в школі відібрали зразки харчових продуктів та питної води, взяли гігієнічні змиви з об’єктів довкілля, обстежили працівників харчоблоку школи. Поліція розпочала перевірку ймовірного харчового отруєння учнів.
3 березня заступниця міського голови Житомира Марія Місюрова інформувала, що четверо з восьми пацієнтів-школярів, які перебували у дитячій лікарні, були виписані. Попередній діагноз «кишкова інфекція» у них не підтвердився. Станом на 5 березня, усі учні школи №20 були виписані з лікарні.
17 березня Держпродспоживслужба в Житомирській області оприлюднила заключну інформацію по спалаху гострої кишкової інфекції, що виник у спеціалізованій школі І-ІІІ ступеню №20 міста Житомира: у половині відібраних змивів виявили стафілокок та кишкову паличку.
У вересні 2021 у житомирській школі №20 показали оновлений харчоблок і розповіли, що замінили підприємця, який годував учнів.




























